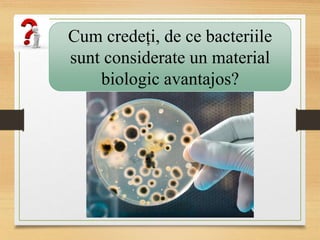
Cum credeți, de ce bacteriile
sunt considerate un material
biologic avantajos?

Documentul discută despre virusuri și bacterii, evidențiind caracteristicile acestora, etapele multiplicării virusurilor și rolul bacteriilor în viața umană și ecosistem. Se menționează diferențele între organismele procariote și eucariote, precum și utilitatea bacteriilor de fermentație în industria alimentară. De asemenea, sunt incluse studii de caz despre boli cauzate de bacterii și regulile de igienă pentru prevenirea infecțiilor.